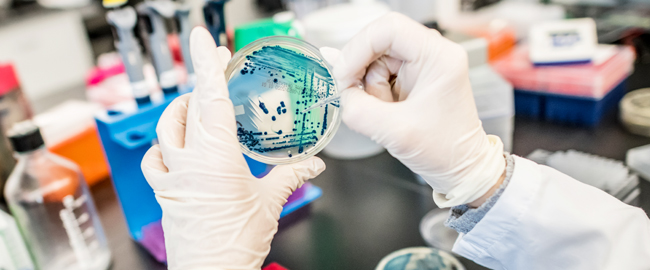
Institute for Quality Science

About HMH Research Institute
Center for Discovery and Innovation
Translating current innovations in science to improve clinical outcomes for patients. Learn more.

Office of Research Administration
Find research resources, grants, and support for researchers, participants, and sponsors. Contact us today for assistance.

Office of Innovation & Commercialization
Advance healthcare innovation. Get support for inventions, patents, and commercialization. Submit your invention today.
Institute for Quality Science
Improve healthcare quality and safety. The Institute for Quality Science leads research and education initiatives. Learn more and support our work.

Research Compliance
Advance medical science responsibly. Our research team ensures ethical and compliant studies. Contact us for information.

Research Roundup Newsletter
Discover the latest medical research advancements. Read the Winter 2025 Research Roundup newsletter featuring new grants, publications, and collaborations.